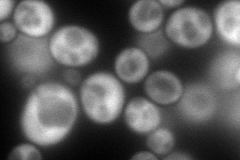
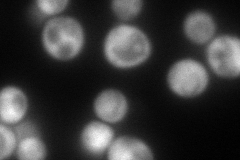
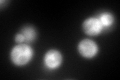

View description
eIF3a subunit of the core complex of translation initiation factor 3 (eIF3), essential for translation; part of a subcomplex (Prt1p-Rpg1p-Nip1p) that stimulates binding of mRNA and tRNA(i)Met to ribosomes
Localization:
Intensity:
Fold change:
Significance:
-
C’ GFP library in SD

cytosol186.81 -
N' NOP1pr-GFP in SD
cytosol235.459 -
N' TEF2pr-mCherry in SD
cytosol224.078 -
N' NATIVEpr-GFP in SD

punctate23.8776 -
N' TEF2pr-VC and Cyto-VN in SD

#N/A0 -
C’ GFP library in SD+DTT
cytosol148.450.79No -
C’ GFP library in SD+H2O2

cytosol175.470.93No -
C’ GFP library in Starvation Media

cytosol98.650.52Yes -
C’ GFP library on the background of Pup2-DaMP

cytosol -
C’ GFP library on the background of CCT mutant

cytosol198.4841.06248No
